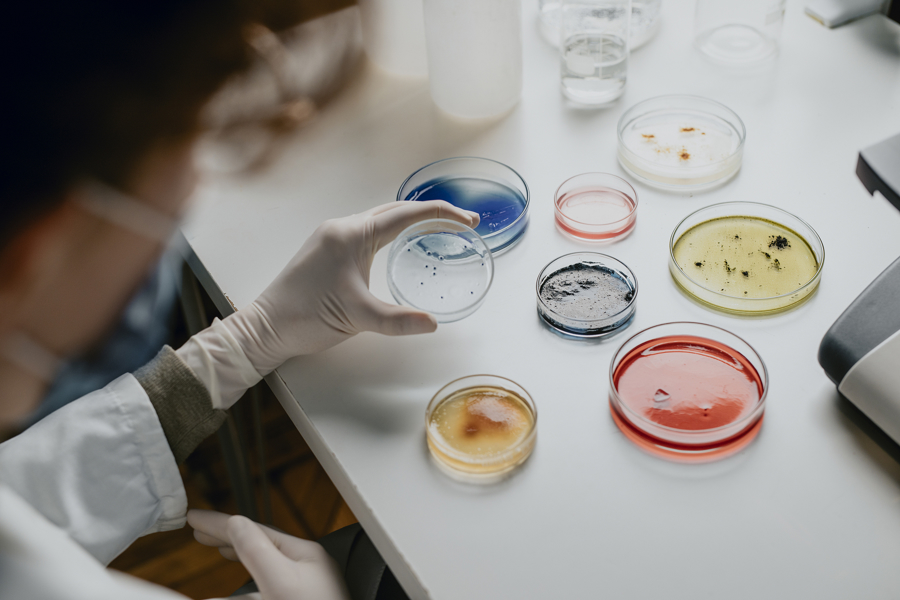

图/视觉中国
图/视觉中国
在微观世界的隐秘角落里,一个典型细菌的直径仅约1微米,相当于人类头发丝粗细的百分之一。然而,这些看似微小的生命形式,却拥有惊人的适应能力和生存智慧——它们无处不在,就连人体也是它们繁衍生息的场所。
在人类文明的历史长河中,包括细菌在内的微生物群落,一直与我们进行着无声的对话,除了发酵与瘟疫,它们还在悄无声息地影响着人类健康。
早在1700多年前,我国东晋名医葛洪在《肘后备急方》中“以粪清治疗食物中毒和严重腹泻”的记载,就是人类利用人体肠道共生微生物治疗疾病的朴素实践。2023年,全球首款基于粪菌移植原理、用于治疗复发性艰难梭菌感染的口服粪便微生物药物VOWST(SER-109)获批上市。
从传统医学的经验性探索到现代精准医疗的机制性突破,这一相隔千年的时空链接,展现了人类对生命奥秘认知的螺旋式上升。
隐身小伙伴,从“看不见”到“被看见”
早在公元前36年,罗马政治家马库斯·瓦罗就在其著作《论农业》中提出了类似“细菌”的概念:环境中存在着肉眼看不见的微小活物,它们悄无声息地通过口鼻进入人体,引发严重疾病。这样的观点在当时显得惊世骇俗,因为绝大多数人相信疾病是由超自然力量或瘴气等原因所致。
直到17世纪,人们才通过严谨的实验观察,证实微生物的存在。1665年,英国科学家罗伯特·胡克首次使用显微镜发现了真核细胞结构,随后在《显微图志》中首次使用了“细胞”一词。与胡克同时期的荷兰人安东尼·列文虎克,则首次观察到了水滴中的细菌和原生动物等微生物,彻底颠覆了人们对生命世界的传统认知。不仅如此,他还第一次在人体口腔碎屑中发现了大量共生微生物。
虽然早在数千年前人类就掌握了酿酒、酿醋的技艺,但古人对发酵原理并不了解。直到19世纪中叶,法国科学巨匠路易斯·巴斯德提出,发酵的本质是微生物在进行代谢活动。1857年,他发表经典论文《关于乳酸发酵的记录》,并通过一系列实验证明不同微生物的代谢活动决定了发酵产物的性质——酵母菌产生酒精,乳酸菌生成乳酸,而腐败菌则分解有机物产生臭味物质。
而美国古生物学家与解剖学家约瑟夫·莱迪在解剖动物肠道时,首次系统记录了动物体内的微生物群落,为人类以后提出“微生物组”这一概念埋下伏笔。
又过了半个世纪,1907年,俄国免疫学家与微生物学家伊拉·梅契尼科夫从保加利亚农民的长寿现象中发现,酸奶中的乳酸菌能抑制肠道腐败菌生长,由此提出“衰老源于自身中毒”的理论,开创了益生菌研究的先河。
1917年,德国医学微生物学家阿尔弗雷德·尼塞尔在欧洲战场上救治痢疾病人时,从一名士兵的健康粪便中分离出一株被命名为“Nissle 1917”的益生菌,在那个抗生素尚未问世的时代,它成为治疗肠道感染的天然武器。
这些突破性发现本应推动微生物组研究进入快车道,却被19世纪末至20世纪初横行的流感、霍乱、结核病等传染病耽误——当医生和科学家忙着用抗生素对抗致病“坏细菌”时,谁会关注肠道里那些看不见的“好细菌”呢?
重塑认知边界,揭秘人体“第二基因组”
1953年, DNA双螺旋结构的发现推动了生命科学各领域的范式变革。DNA序列分析技术的兴起,为微生物分类学提供了分子水平的精准标尺,开启了基于遗传信息的微生物系统发育研究新纪元。
上世纪60年代末,美国微生物学家卡尔·乌斯首次构建了涵盖细菌、古菌和真核生物的三域生命树。他的工作不仅确立了古菌作为独立生命域的地位,还发展起一系列方法为微生物学提供了标准化、可量化的分类工具,使科学家能够准确识别不同生态环境中的未知微生物。
又过了约20年,DNA测序技术的进步推动了微生物研究从“物种鉴定”向“群落解析”的跨越。美国科学家诺曼·佩斯开创性地提出可直接提取环境样本(如土壤、水体、人体肠道)中的总DNA(即宏基因组),并分析出微生物群落的结构组成。这一方法首次揭示了自然界中大量“不可培养微生物”的存在。1985年,佩斯团队利用该技术分析美国黄石公园热泉微生物群落,首次证实极端环境中微生物多样性的丰富程度远超预期。
 图/视觉中国
图/视觉中国
这些奠基性的研究突破直接催生了后续的人类微生物组计划、地球微生物组计划等国际大科学项目。从单一微生物的“身份识别”到整个微生物组的“结构解码”,两位先驱的工作彻底重塑了人类对生命微观世界的认知边界。
随着基因组时代到来,科学家发现,人体内共生微生物的基因总量是人类基因组的上百倍,其功能与影响却被长期忽视。为填补这一认知空白,2007年美国国立卫生研究院启动了人类微生物组计划,以揭示我们的“第二基因组”对人类生理与病理的深远影响。
该计划整合了微生物学、宏基因组学、代谢组学、转录组学、生物信息学、临床医学等不同领域的技术与理论,推动研究从“描述性”向“关联性”跨越。它首次揭示健康人体微生物组的复杂性,进一步颠覆了“微生物仅是病原体”的传统观念,并揭示出微生物组失衡与疾病进展存在直接关联,更为开发基于微生物组的精准医疗策略奠定了科学基础,如益生菌疗法、粪便移植技术等。
例如,该计划发现早产孕妇阴道内乳酸菌减少、感染相关性细菌增多,且这些微生物组成的变化与维生素D缺乏相关;炎症性肠病患者肠道中兼性厌氧菌增加、专性厌氧菌减少,且这些变化与微生物代谢活动及宿主免疫反应相关。
人菌共生,携手维护免疫屏障
本世纪初,科学家在探索共生微生物对机体代谢影响的同时,也开始关注共生微生物与宿主免疫系统的相互作用。
20世纪中叶,现代人体微生物组研究迎来了两项关键技术突破——厌氧微生物培养技术和无菌动物模型技术,这为后续机理探索奠定了坚实基础。美国生物学家杰弗里·戈登实验室以此为基础,率先将微生物组高通量测序、厌氧微生物培养及无菌动物模型三大技术深度整合,开创了微生物组研究新范式。
戈登实验室的一系列研究揭示了肠道共生微生物与人体代谢的深层关联。例如,在肥胖研究中,他们通过高通量测序发现肥胖人群肠道菌群存在特征性改变,当将肥胖患者的粪便菌群移植给无菌小鼠后,小鼠的脂肪积累速度也会加快,由此证明肠道微生物可直接调控宿主的能量吸收。
针对儿童营养不良,戈登实验室将一些营养不良儿童的粪便移植到无菌小鼠体内,这些小鼠也随之发生体重增加减缓,骨骼发育不良及多种代谢、免疫异常症状。这些突破性发现构建了“菌群-代谢-疾病”的完整链条,为后续开发更有效的营养干预策略提供了理论支撑。
2009年,美国免疫学家丹·利特曼实验室发现,一种名为分节丝状菌的肠道革兰氏阳性细菌能够诱导产生一群具有增强炎症反应功能的特殊辅助性T细胞,即Th17细胞。随后,日本科学家本田贤也的实验室也很快报道,肠道共生梭菌可诱导产生一群具有免疫抑制功能的特殊调节性T细胞,即Treg细胞。
 图/Pixabay
图/Pixabay
这两个实验室的开创性工作表明,不同种属的共生微生物对机体肠道黏膜免疫系统具有正负两方面的调控作用,从而维持肠道黏膜免疫应答反应的阴阳平衡。
那么,肠道内的共生微生物究竟是如何调控我们的免疫系统的呢?早在20世纪70年代,美国微生物学家及免疫学家丹尼斯·卡斯帕在研究细菌感染的过程中意识到,共生微生物可能参与了感染进程。在人类肠道中定殖的数百种共生微生物中,对青霉素有耐药性的脆弱拟杆菌是从感染部位分离出的最常见的微生物。他的实验室首次报道,这种共生菌表面的八种荚膜多糖可能赋予其独特的免疫原性,从而影响机体健康。
经过长达近30年的研究,卡斯帕实验室于2008年最终证明,来自脆弱拟杆菌的荚膜多糖A是介导其免疫调节功能的主要分子。这一发现为理解共生微生物如何通过具体活性分子来调节机体免疫力提供了重要实验证据,开启了共生微生物与机体免疫力因果关系分子机理研究的新篇章。
新技术孕育变革,下一代益生菌已在路上
从显微镜的发明到基因测序技术的发展,从无菌动物的创建到厌氧微生物遗传操作技术的成熟,人类微生物组研究的每一次突破都伴随着技术革新,新型研究方法已在悄悄酝酿人体共生微生物组研究的下一轮变革。
2023年,我国牵头启动了全球“未培养微生物培养组”计划。尽管目前我们对人体内共生微生物群落有了较为全面的了解,但仍有大量微生物因生长条件极为特殊而难以在实验室条件下进行培养。该研究计划旨在通过开发新的培养技术和方法,对那些尚未培养的微生物进行分离、培养和功能鉴定。
这些未培养微生物可能蕴藏着独特的代谢功能和生物学特性,对人体健康和疾病的发生发展或许有着不可忽视的影响。通过未培养组计划的实施,我们有望发现新的微生物种类和功能基因,进一步丰富和完善人体共生微生物组图谱,为深入探究微生物与人体之间的相互作用提供更全面、准确的信息。
随着基因编辑技术的持续进步,如何实现针对不同门类共生微生物的基因编辑正成为当下研究热点。未来,可通过对人体微生物组的深度改造与精准操控,来增强人体健康。比如,我们可通过设计改造共生微生物的基因元件,使其产生更多对人体有益的代谢产物,帮助人体更好抵御疾病。
同时,针对益生菌开展基因编辑也大有可为。通过编辑益生菌基因,可提升其在人体内的定殖能力及合成有益代谢产物的能力,让它们更长久有效地发挥作用。此外,相关技术也将为开发新型微生物疗法开辟新路径,未来有望在治疗免疫或代谢疾病等多种复杂病症中取得关键突破。
在生命科学蓬勃发展的当下,人工智能技术凭借卓越的数据处理与分析能力,已然成为推动该领域前进的关键力量。人体微生物组研究每天都会产生海量数据,人工智能技术就像一个超级侦探,能从纷繁复杂的数据中找出微生物组与人体健康、疾病之间的潜在关联和内在规律。通过建立精准的预测模型,人工智能可根据微生物组的结构和代谢特征,提前预测疾病发生的风险、发展的进程,以及对治疗的反应,为制定个性化医疗方案提供有力依据。
不仅如此,人工智能算法还能挖掘未知的微生物基因功能元件,鉴定潜在微生物代谢途径及其产物,为科研人员设计新型微生物疗法和药物提供思路,加速基础研究成果从实验室到临床的转化应用。
(作者为中国科学院分子细胞科学卓越创新中心研究员)
淘配网提示:文章来自网络,不代表本站观点。